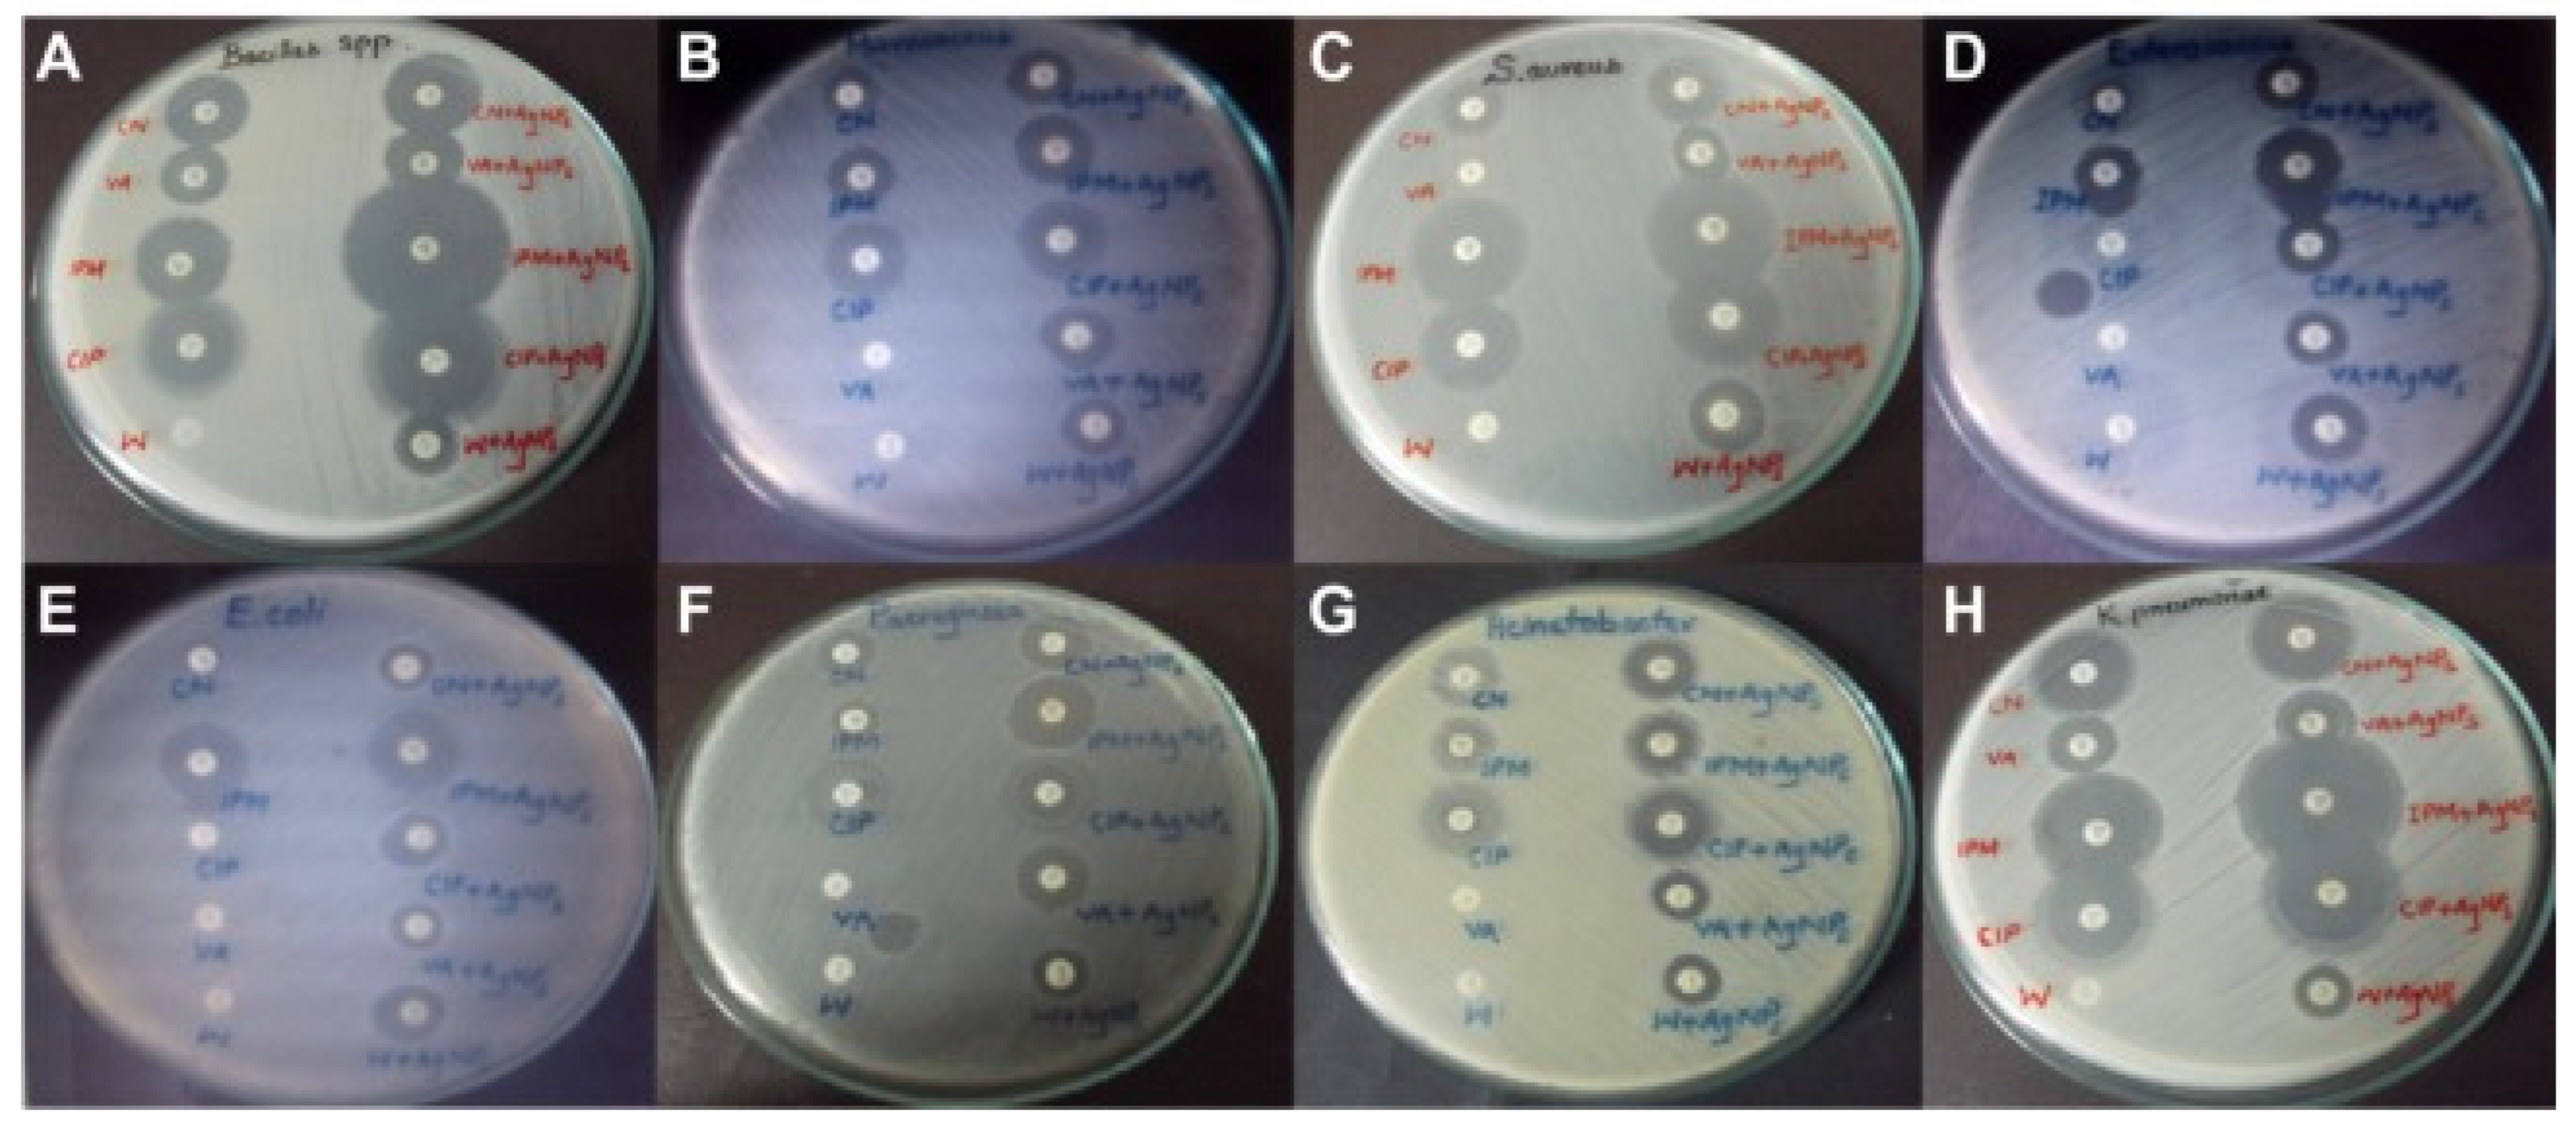
Biosensors 12 01155 g005 Biosensors 12 01155 g005

Recent Advances in Nanotechnology for the Management of Klebsiella pneumoniae–Related Infections
Abstract
1. Introductions
2. Traditional Detection and Treatment Methods
3. Nanotechnology-Assisted Approaches for Effective Detection of K. pneumoniae
3.1. Nanoparticle-Assisted Multiple Cross-Displacement Amplification
3.2. Nanoparticle-Assisted Loop-Mediated Isothermal Amplification
3.3. Optical Nanosensors
3.4. Cantilevers-Based Nanosensors
3.5. Electrochemical Nanosensors
3.6. Biomimetic Nanosensors
4. The Application of Nanomaterials for Treatment of Klebsiella pneumoniae
| Substrates | NP Size (nm) | Key Features | Ref. |
|---|---|---|---|
| Ag-rifampicin | 15–18 | Greater antimicrobial effect than free drug | [125] |
| Ag | 29–50 | High antibacterial effect | [126] |
| Au-imipenem | 12–27 | Strong synergistic antibacterial effect | [127] |
| Ag | 34–90 | Low minimal inhibitory concentration | [128,129] |
| Ag | 3 | 100% bactericidal effect at 0.05 g/mL | [130] |
| TiO2 and Ag | 20 and 90 | Antibiotics and nanoparticles are combined; they have a synergistic impact | [131] |
| TiO2 | - | High antibacterial activity | [132] |
| TiO2 | 50 and 100 | Good antibacterial nature | [133] |
| TiO2 + L. lactis | - | Reliable and operative inorganic antimicrobial agents | [134] |
| CML@Ag-NPs and CML@Au-NPs | 40–60 | Obtained MIC values for Ag and Au NPs were 0.5 and 370 ppm | [135] |
| Ag/AgCl-imipenem (IPM) | 55-89 | Synergetic effect between the IPM antibiotic and Ag/AgCl NPs | [136] |
| ZnO | 6–18 | The antibacterial effectiveness of ZnO NPs-E was 40 g/mL, which was higher than previously reported values | [137] |
| ZnO | 94 | Low MIC and MBC in comparison with those obtained for imipenem and meropenem antibiotics | [138] |
| ZnO | 11–25 | During a lunar eclipse, ZnO NPs have a better antimicrobial activity than on a regular day | [139] |
| Cy-da/ZnO | 29–35 | The highest antibacterial activity for Cy-da/ ZnO NPs in comparison with ZnO NPs | [140] |
| ZnO | 45–50 | Green synthesis with proper size | [141] |
| ZnO | 88 | At dosages of 0.50 to 0.75 mM, the NPs-treated K. pneumoniae was five times less infectious | [142] |
| ZnO/bovine serum albumin(BSA) | 11 | BSA improved antibacterial effect of ZnO NPs | [143] |
| ZnO/Zeolite | - | In sublethal levels, it has strong antibiofilm efficacy against K. pneumoniae | [144] |
| Ag/ZnO | 143 and 154 | The toxicity of nanoparticles strongly depend on surface charge effect | [145] |
| ZnO | 90–110 | Eco-friendly and simple method for synthesis of ZnO NPs | [146] |
| Fe/Co-ZnO | - | 6% Fe and 4% doped ZnO show the maximum antibacterial effect | [147] |
| Carbon cloth/Ag/ZnO | - | Cloth carbons improved antibacterial activity of metal or metal oxide NPs | [148] |
| Ga-ZnO | - | The bioactivity of undoped and Ga-ZnO nanocrystals is significantly improved | [149] |
| Ag@SiO2 | 118 | Antibacterial activity greater than than Ag and SiO2 NPs separately | [150] |
| Mn-TiO2 | 150 | 100% reduction of Klebsiella pneumoniae within 120 min under sunlight | [151] |
| Ag-TiO2 | 163 | Superior antimicrobial activities to Ag and TiO2 | [152] |
| N-TiO2, C-TiO2, N-T-TiO2, and Pd-C-TiO2 | 5–60 | Under visible-light irradiation, Pd-C-TiO2 had the maximum capacity for bacterial inactivation | [153] |
| Au-Ag | 12–67 | The synthesis procedure is environmentally benign because it does not use any solvents or harmful chemicals | [154] |
| Au | 5.5–10 | Remarkable bactericidal activities against polymyxin-resistant Klebsiella pneumoniae, which are superior to clinical antibiotics | [155] |
| Fe3O4 | 24 | Good additional antimicrobial | [156] |
5. Conclusions, Challenges and Future Perspective
Author Contributions
Funding
Institutional Review Board Statement
Informed Consent Statement
Data Availability Statement
Conflicts of Interest
References
- Morens, D.M.; Folkers, G.K.; Fauci, A.S. The challenge of emerging and re-emerging infectious diseases. Nature 2004, 430, 242–249. [Google Scholar] [CrossRef]
- Millet, J.-P.; Moreno, A.; Fina, L.; Del Baño, L.; Orcau, A.; De Olalla, P.G.; Cayla, J.A. Factors that influence current tuberculosis epidemiology. Eur. Spine J. 2013, 22, 539–548. [Google Scholar] [CrossRef] [PubMed]
- Andrade, F.; Rafael, D.; Videira, M.; Ferreira, D.; Sosnik, A.; Sarmento, B. Nanotechnology and pulmonary delivery to overcome resistance in infectious diseases. Adv. Drug Deliv. Rev. 2013, 65, 1816–1827. [Google Scholar] [CrossRef] [PubMed]
- Rock, C.; Thom, K.A.; Masnick, M.; Johnson, J.K.; Harris, A.D.; Morgan, D.J. Frequency of Klebsiella pneumoniae Carbapenemase (KPC)–producing and Non-KPC-producing klebsiella species contamination of healthcare workers and the environment. Infect. Control Hosp. Epidemiol. 2014, 35, 426–429. [Google Scholar] [CrossRef] [PubMed]
- Friedländer, C. Ueber die Schizomyceten bei der acuten fibrösen Pneumonie. Arch. Für Pathol. Anat. Und Physiol. Und Für Klin. Med. 1882, 87, 319–324. [Google Scholar]
- Clegg, S.; Murphy, C.N. Epidemiology and virulence of Klebsiella pneumoniae. Urin. Tract Infect. Mol. Pathog. Clin. Manag. 2017, 4, 435–457. [Google Scholar]
- Vuotto, C.; Longo, F.; Balice, M.P.; Donelli, G.; Varaldo, P.E. Antibiotic resistance related to biofilm formation in Klebsiella pneumoniae. Pathogens 2014, 3, 743–758. [Google Scholar] [CrossRef]
- Sargazi, G.; Afzali, D.; Ghafainazari, A.; Saravani, H. Rapid synthesis of cobalt metal organic framework. J. Inorg. Organomet. Polym. Mater. 2014, 24, 786–790. [Google Scholar] [CrossRef]
- Paczosa, M.K.; Mecsas, J. Klebsiella pneumoniae: Going on the offense with a strong defense. Microbiol. Mol. Biol. Rev. 2016, 80, 629–661. [Google Scholar] [CrossRef]
- Ko, W.-C.; Paterson, D.L.; Sagnimeni, A.J.; Hansen, D.S.; Von Gottberg, A.; Mohapatra, S.; Casellas, J.M.; Goossens, H.; Mulazimoglu, L.; Trenholme, G. Community-acquired Klebsiella pneumoniae bacteremia: Global differences in clinical patterns. Emerg. Infect. Dis. 2002, 8, 160. [Google Scholar] [CrossRef]
- Gross, A.E.; Van Schooneveld, T.C.; Olsen, K.M.; Rupp, M.E.; Bui, T.H.; Forsung, E.; Kalil, A.C. Epidemiology and predictors of multidrug-resistant community-acquired and health care-associated pneumonia. Antimicrob. Agents Chemother. 2014, 58, 5262–5268. [Google Scholar] [CrossRef] [PubMed]
- Podschun, R.; Ullmann, U. Klebsiella spp. as nosocomial pathogens: Epidemiology, taxonomy, typing methods, and pathogenicity factors. Clin. Microbiol. Rev. 1998, 11, 589–603. [Google Scholar] [CrossRef] [PubMed]
- Russo, T.A.; Olson, R.; Fang, C.-T.; Stoesser, N.; Miller, M.; MacDonald, U.; Hutson, A.; Barker, J.H.; La Hoz, R.M.; Johnson, J.R. Identification of biomarkers for differentiation of hypervirulent Klebsiella pneumoniae from classical K. pneumoniae. J. Clin. Microbiol. 2018, 56, e00776-18. [Google Scholar] [CrossRef] [PubMed]
- Boucher, H.W.; Talbot, G.H.; Bradley, J.S.; Edwards, J.E.; Gilbert, D.; Rice, L.B.; Scheld, M.; Spellberg, B.; Bartlett, J. Bad bugs, no drugs: No ESKAPE! An update from the Infectious Diseases Society of America. Clin. Infect. Dis. 2009, 48, 1–12. [Google Scholar] [CrossRef] [PubMed]
- Kuehn, B.M. “Nightmare” bacteria on the rise in US hospitals, long-term care facilities. Jama 2013, 309, 1573–1574. [Google Scholar] [PubMed]
- Pidot, S.J.; Coyne, S.; Kloss, F.; Hertweck, C. Antibiotics from neglected bacterial sources. Int. J. Med. Microbiol. 2014, 304, 14–22. [Google Scholar] [CrossRef] [PubMed]
- Bradley, J.S.; Guidos, R.; Baragona, S.; Bartlett, J.G.; Rubinstein, E.; Zhanel, G.G.; Tino, M.D.; Pompliano, D.L.; Tally, F.; Tipirneni, P. Anti-infective research and development—problems, challenges, and solutions. Lancet Infect. Dis. 2007, 7, 68–78. [Google Scholar] [CrossRef]
- Yigit, H.; Queenan, A.M.; Anderson, G.J.; Domenech-Sanchez, A.; Biddle, J.W.; Steward, C.D.; Alberti, S.; Bush, K.; Tenover, F.C. Novel carbapenem-hydrolyzing β-lactamase, KPC-1, from a carbapenem-resistant strain of Klebsiella pneumoniae. Antimicrob. Agents Chemother. 2001, 45, 1151–1161. [Google Scholar] [CrossRef]
- Jeffs, M.A.; Lohans, C.T. Inhibiting the metallo-β-lactamases: Challenges and strategies to overcome bacterial β-lactam resistance. Future Med Chem. 2022, 14, 1021–1025. [Google Scholar] [CrossRef]
- Queenan, A.M.; Bush, K. Carbapenemases: The versatile β-lactamases. Clin. Microbiol. Rev. 2007, 20, 440–458. [Google Scholar] [CrossRef]
- Paterson, D.L. Resistance in gram-negative bacteria: Enterobacteriaceae. Am. J. Infect. Control 2006, 34, S20–S28. [Google Scholar] [CrossRef]
- Rasheed, J.K.; Biddle, J.W.; Anderson, K.F.; Washer, L.; Chenoweth, C.; Perrin, J.; Newton, D.W.; Patel, J.B. Detection of the Klebsiella pneumoniae carbapenemase type 2 carbapenem-hydrolyzing enzyme in clinical isolates of Citrobacter freundii and K. oxytoca carrying a common plasmid. J. Clin. Microbiol. 2008, 46, 2066–2069. [Google Scholar] [CrossRef] [PubMed][Green Version]
- Yu, X.; Zhang, W.; Zhao, Z.; Ye, C.; Zhou, S.; Wu, S.; Han, L.; Han, Z.; Ye, H. Molecular characterization of carbapenem-resistant Klebsiella pneumoniae isolates with focus on antimicrobial resistance. BMC Genom. 2019, 20, 822. [Google Scholar] [CrossRef]
- Cannatelli, A.; Santos-Lopez, A.; Giani, T.; Gonzalez-Zorn, B.; Rossolini, G.M. Polymyxin resistance caused by mgrB inactivation is not associated with significant biological cost in Klebsiella pneumoniae. Antimicrob. Agents Chemother. 2015, 59, 2898–2900. [Google Scholar] [CrossRef]
- Roth, G.A.; Abate, D.; Abate, K.H.; Abay, S.M.; Abbafati, C.; Abbasi, N.; Abbastabar, H.; Abd-Allah, F.; Abdela, J.; Abdelalim, A. Global, regional, and national age-sex-specific mortality for 282 causes of death in 195 countries and territories, 1980–2017: A systematic analysis for the Global Burden of Disease Study 2017. Lancet 2018, 392, 1736–1788. [Google Scholar] [CrossRef]
- Nagel, T.E.; Chan, B.K.; De Vos, D.; El-Shibiny, A.; Kang’ethe, E.K.; Makumi, A.; Pirnay, J.-P. The developing world urgently needs phages to combat pathogenic bacteria. Front. Microbiol. 2016, 7, 882. [Google Scholar] [CrossRef] [PubMed]
- Reid, G.; Jass, J.; Sebulsky, M.T.; McCormick, J.K. Potential uses of probiotics in clinical practice. Clin. Microbiol. Rev. 2003, 16, 658–672. [Google Scholar] [CrossRef] [PubMed]
- Hosseinikhah, S.M.; Barani, M.; Rahdar, A.; Madry, H.; Arshad, R.; Mohammadzadeh, V.; Cucchiarini, M. Nanomaterials for the diagnosis and treatment of inflammatory arthritis. Int. J. Mol. Sci. 2021, 22, 3092. [Google Scholar] [CrossRef]
- Qindeel, M.; Barani, M.; Rahdar, A.; Arshad, R.; Cucchiarini, M. Nanomaterials for the diagnosis and treatment of urinary tract infections. Nanomaterials 2021, 11, 546. [Google Scholar] [CrossRef]
- Lai, W.-F. Non-conjugated polymers with intrinsic luminescence for drug delivery. J. Drug Deliv. Sci. Technol. 2020, 59, 101916. [Google Scholar] [CrossRef]
- Lai, W.-F.; Wong, W.-T. Use of graphene-based materials as carriers of bioactive agents. Asian J. Pharm. Sci. 2021, 16, 577–588. [Google Scholar] [CrossRef]
- Almansob, A.; Bahkali, A.H.; Albarrag, A.; Alshomrani, M.; Binjomah, A.; Hailan, W.A.; Ameen, F. Effective treatment of resistant opportunistic fungi associated with immuno-compromised individuals using silver biosynthesized nanoparticles. Appl. Nanosci. 2022, 12, 3871–3882. [Google Scholar] [CrossRef] [PubMed]
- Cao, Y.; Abbasi, M.; Alijani, H.Q.; Akbarizadeh, M.R.; Iravani, S.; Barani, M.; Najafi, K.; Khatami, S.; Khatami, M. Ceramic magnetic ferrite nanoribbons: Eco-friendly synthesis and their antifungal and parasiticidal activity. Ceram. Int. 2022, 48, 3448–3454. [Google Scholar] [CrossRef]
- Barani, M.; Rahdar, A.; Sargazi, S.; Amiri, M.S.; Sharma, P.K.; Bhalla, N. Nanotechnology for inflammatory bowel disease management: Detection, imaging and treatment. Sens. Bio-Sens. Res. 2021, 32, 100417. [Google Scholar] [CrossRef]
- Arkaban, H.; Barani, M.; Akbarizadeh, M.R.; Pal Singh Chauhan, N.; Jadoun, S.; Dehghani Soltani, M.; Zarrintaj, P. Polyacrylic acid nanoplatforms: Antimicrobial, tissue engineering, and cancer theranostic applications. Polymers 2022, 14, 1259. [Google Scholar] [CrossRef]
- Moghadam, N.C.Z.; Jasim, S.A.; Ameen, F.; Alotaibi, D.H.; Nobre, M.A.; Sellami, H.; Khatami, M. Nickel oxide nanoparticles synthesis using plant extract and evaluation of their antibacterial effects on Streptococcus mutans. Bioprocess Biosyst. Eng. 2022, 45, 1201–1210. [Google Scholar] [CrossRef]
- Satarzadeh, N.; Shakibaie, M.; Adeli-Sardou, M.; Jabari-Morouei, F.; Forootanfar, H.; Sadeghi-Dousari, A. Facile Microwave-Assisted Biosynthesis of Arsenic Nanoparticles and Evaluation their Antioxidant Properties and Cytotoxic Effects: A Preliminary in Vitro Study. J. Clust. Sci. 2022, 1–9. [Google Scholar] [CrossRef]
- Jadoun, S.; Chauhan, N.P.S.; Zarrintaj, P.; Barani, M.; Varma, R.S.; Chinnam, S.; Rahdar, A. Synthesis of nanoparticles using microorganisms and their applications: A review. Environ. Chem. Lett. 2022, 20, 3153–3197. [Google Scholar] [CrossRef]
- Blecher, K.; Nasir, A.; Friedman, A. The growing role of nanotechnology in combating infectious disease. Virulence 2011, 2, 395–401. [Google Scholar] [CrossRef]
- Rastegar, S.; Moradi, M.; Kalantar-Neyestanaki, D.; Hosseini-Nave, H. Virulence factors, capsular serotypes and antimicrobial resistance of hypervirulent Klebsiella pneumoniae and classical Klebsiella pneumoniae in Southeast Iran. Infect. Chemother. 2019, 51, e39. [Google Scholar] [CrossRef]
- Spanu, T.; Fiori, B.; D’Inzeo, T.; Canu, G.; Campoli, S.; Giani, T.; Palucci, I.; Tumbarello, M.; Sanguinetti, M.; Rossolini, G.M. Evaluation of the new NucliSENS EasyQ KPC test for rapid detection of Klebsiella pneumoniae carbapenemase genes (bla KPC). J. Clin. Microbiol. 2012, 50, 2783–2785. [Google Scholar] [CrossRef] [PubMed][Green Version]
- Peter, H.; Berggrav, K.; Thomas, P.; Pfeifer, Y.; Witte, W.; Templeton, K.; Bachmann, T.T. Direct detection and genotyping of Klebsiella pneumoniae carbapenemases from urine by use of a new DNA microarray test. J. Clin. Microbiol. 2012, 50, 3990–3998. [Google Scholar] [CrossRef] [PubMed]
- Lee, T.D.; Adie, K.; McNabb, A.; Purych, D.; Mannan, K.; Azana, R.; Ng, C.; Tang, P.; Hoang, L.M. Rapid detection of KPC, NDM, and OXA-48-like carbapenemases by real-time PCR from rectal swab surveillance samples. J. Clin. Microbiol. 2015, 53, 2731–2733. [Google Scholar] [CrossRef] [PubMed]
- Köser, C.U.; Fraser, L.J.; Ioannou, A.; Becq, J.; Ellington, M.J.; Holden, M.T.; Reuter, S.; Török, M.E.; Bentley, S.D.; Parkhill, J. Rapid single-colony whole-genome sequencing of bacterial pathogens. J. Antimicrob. Chemother. 2014, 69, 1275–1281. [Google Scholar] [CrossRef]
- Willemse-Erix, D.; Bakker-Schut, T.; Slagboom-Bax, F.; Jachtenberg, J.-W.; Lemmens-den Toom, N.; Papagiannitsis, C.C.; Kuntaman, K.; Puppels, G.; van Belkum, A.; Severin, J.A. Rapid typing of extended-spectrum β-lactamase-and carbapenemase-producing Escherichia coli and Klebsiella pneumoniae isolates by use of SpectraCell RA. J. Clin. Microbiol. 2012, 50, 1370–1375. [Google Scholar] [CrossRef] [PubMed][Green Version]
- Nakano, R.; Nakano, A.; Ishii, Y.; Ubagai, T.; Kikuchi-Ueda, T.; Kikuchi, H.; Tansho-Nagakawa, S.; Kamoshida, G.; Mu, X.; Ono, Y. Rapid detection of the Klebsiella pneumoniae carbapenemase (KPC) gene by loop-mediated isothermal amplification (LAMP). J. Infect. Chemother. 2015, 21, 202–206. [Google Scholar] [CrossRef]
- Carvalhaes, C.G.; Cayô, R.; Visconde, M.F.; Barone, T.; Frigatto, E.A.; Okamoto, D.; Assis, D.M.; Juliano, L.; Machado, A.M.; Gales, A.C. Detection of carbapenemase activity directly from blood culture vials using MALDI-TOF MS: A quick answer for the right decision. J. Antimicrob. Chemother. 2014, 69, 2132–2136. [Google Scholar] [CrossRef]
- Girlich, D.; Anglade, C.; Zambardi, G.; Nordmann, P. Comparative evaluation of a novel chromogenic medium (chromID OXA-48) for detection of OXA-48 producing Enterobacteriaceae. Diagn. Microbiol. Infect. Dis. 2013, 77, 296–300. [Google Scholar] [CrossRef]
- Hirsch, E.B.; Tam, V.H. Detection and treatment options for Klebsiella pneumoniae carbapenemases (KPCs): An emerging cause of multidrug-resistant infection. J. Antimicrob. Chemother. 2010, 65, 1119–1125. [Google Scholar] [CrossRef]
- Humphries, R.; Bobenchik, A.M.; Hindler, J.A.; Schuetz, A.N. Overview of Changes to the Clinical and Laboratory Standards Institute Performance Standards for Antimicrobial Susceptibility Testing, M100. J. Clin. Microbiol. 2021, 59, e00213–e00221. [Google Scholar] [CrossRef]
- Yagi, T.; Wachino, J.-i.; Kurokawa, H.; Suzuki, S.; Yamane, K.; Doi, Y.; Shibata, N.; Kato, H.; Shibayama, K.; Arakawa, Y. Practical methods using boronic acid compounds for identification of class C β-lactamase-producing Klebsiella pneumoniae and Escherichia coli. J. Clin. Microbiol. 2005, 43, 2551–2558. [Google Scholar] [CrossRef] [PubMed]
- Xu, W.; Shang, Y. The Detection Techniques of Genetically Modified Organisms. In Genetically Modified Organisms in Food; Elsevier Academic Press: Cambridge, MA, USA, 2015; pp. 343–351. [Google Scholar]
- Ma, X.; Li, Y.; Liang, Y.; Liu, Y.; Yu, L.; Li, C.; Liu, Q.; Chen, L. Development of a DNA microarray assay for rapid detection of fifteen bacterial pathogens in pneumonia. BMC Microbiol. 2020, 20, 177. [Google Scholar] [CrossRef] [PubMed]
- Rebrosova, K.; Samek, O.; Kizovsky, M.; Bernatova, S.; Hola, V.; Ruzicka, F. Raman Spectroscopy—A Novel Method for Identification and Characterization of Microbes on a Single-Cell Level in Clinical Settings. Front. Cell. Infect. Microbiol. 2022, 367, 866463. [Google Scholar] [CrossRef] [PubMed]
- Wong, Y.P.; Othman, S.; Lau, Y.L.; Radu, S.; Chee, H.Y. Loop-mediated isothermal amplification (LAMP): A versatile technique for detection of micro-organisms. J. Appl. Microbiol. 2018, 124, 626–643. [Google Scholar] [CrossRef] [PubMed]
- Perry, J.; Freydiere, A. The application of chromogenic media in clinical microbiology. J. Appl. Microbiol. 2007, 103, 2046–2055. [Google Scholar] [CrossRef] [PubMed]
- Hong, J.H.; Clancy, C.J.; Cheng, S.; Shields, R.K.; Chen, L.; Doi, Y.; Zhao, Y.; Perlin, D.S.; Kreiswirth, B.N.; Nguyen, M.H. Characterization of porin expression in Klebsiella pneumoniae Carbapenemase (KPC)-producing K. pneumoniae identifies isolates most susceptible to the combination of colistin and carbapenems. Antimicrob Agents Chemother 2013, 57, 2147–2153. [Google Scholar] [CrossRef]
- Stachyra, T.; Levasseur, P.; Péchereau, M.-C.; Girard, A.-M.; Claudon, M.; Miossec, C.; Black, M.T. In vitro activity of the β-lactamase inhibitor NXL104 against KPC-2 carbapenemase and Enterobacteriaceae expressing KPC carbapenemases. J. Antimicrob. Chemother. 2009, 64, 326–329. [Google Scholar] [CrossRef]
- Khan, A.A.; Manzoor, K.N.; Sultan, A.; Saeed, M.; Rafique, M.; Noushad, S.; Talib, A.; Rentschler, S.; Deigner, H.-P. Pulling the brakes on fast and furious multiple drug-resistant (MDR) bacteria. Int. J. Mol. Sci. 2021, 22, 859. [Google Scholar] [CrossRef]
- Cao, F.; Wang, X.; Wang, L.; Li, Z.; Che, J.; Wang, L.; Li, X.; Cao, Z.; Zhang, J.; Jin, L. Evaluation of the efficacy of a bacteriophage in the treatment of pneumonia induced by multidrug resistance Klebsiella pneumoniae in mice. BioMed Res. Int. 2015, 2015, 752930. [Google Scholar] [CrossRef]
- Gondil, V.S.; Chhibber, S. Alternative Therapies: Toolbox to Combat Antibiotic-Resistant Bugs. In Strategies to Overcome Superbug Invasions: Emerging Research and Opportunities; IGI Global: Hershey, PA, USA, 2021; pp. 160–182. [Google Scholar]
- Vieira, A.T.; Rocha, V.M.; Tavares, L.; Garcia, C.C.; Teixeira, M.M.; Oliveira, S.C.; Cassali, G.D.; Gamba, C.; Martins, F.S.; Nicoli, J.R. Control of Klebsiella pneumoniae pulmonary infection and immunomodulation by oral treatment with the commensal probiotic Bifidobacterium longum 51A. Microbes Infect. 2016, 18, 180–189. [Google Scholar] [CrossRef]
- Barani, M.; Zeeshan, M.; Kalantar-Neyestanaki, D.; Farooq, M.A.; Rahdar, A.; Jha, N.K.; Sargazi, S.; Gupta, P.K.; Thakur, V.K. Nanomaterials in the management of gram-negative bacterial infections. Nanomaterials 2021, 11, 2535. [Google Scholar] [CrossRef]
- Alijani, H.Q.; Iravani, S.; Pourseyedi, S.; Torkzadeh-Mahani, M.; Barani, M.; Khatami, M. Biosynthesis of spinel nickel ferrite nanowhiskers and their biomedical applications. Sci. Rep. 2021, 11, 17431. [Google Scholar] [CrossRef] [PubMed]
- Wang, Y.; Wang, Y.; Ma, A.-J.; Li, D.-X.; Luo, L.-J.; Liu, D.-X.; Jin, D.; Liu, K.; Ye, C.-Y. Rapid and sensitive isothermal detection of nucleic-acid sequence by multiple cross displacement amplification. Sci. Rep. 2015, 5, srep11902. [Google Scholar] [CrossRef] [PubMed]
- Wang, Y.; Yan, W.; Wang, Y.; Xu, J.; Ye, C. Rapid, sensitive and reliable detection of Klebsiella pneumoniae by label-free multiple cross displacement amplification coupled with nanoparticles-based biosensor. J. Microbiol. Methods 2018, 149, 80–88. [Google Scholar] [CrossRef] [PubMed]
- Niu, L.; Zhao, F.; Chen, J.; Nong, J.; Wang, C.; Wang, J.; Gao, N.; Zhu, X.; Wu, L.; Hu, S. Isothermal amplification and rapid detection of Klebsiella pneumoniae based on the multiple cross displacement amplification (MCDA) and gold nanoparticle lateral flow biosensor (LFB). PLoS ONE 2018, 13, e0204332. [Google Scholar] [CrossRef] [PubMed]
- Zhao, F.; Niu, L.; Nong, J.; Wang, C.; Wang, J.; Liu, Y.; Gao, N.; Zhu, X.; Wu, L.; Hu, S. Rapid and sensitive detection of Pseudomonas aeruginosa using multiple cross displacement amplification and gold nanoparticle-based lateral flow biosensor visualization. FEMS Microbiol. Lett. 2018, 365, fny147. [Google Scholar] [CrossRef]
- Gong, L.; Liu, E.; Che, J.; Li, J.; Liu, X.; Xu, H.; Liang, J. Multiple cross displacement amplification coupled with gold nanoparticles-based lateral flow biosensor for detection of the mobilized colistin resistance gene mcr-1. Front. Cell. Infect. Microbiol. 2019, 9, 226. [Google Scholar] [CrossRef]
- Niu, H.; Zhang, W.; Wei, L.; Liu, M.; Liu, H.; Zhao, C.; Zhang, P.; Liao, Q.; Liu, Y.; Yuan, Q. Rapid nanopore assay for carbapenem-resistant Klebsiella pneumoniae. Front. Microbiol. 2019, 10, 1672. [Google Scholar] [CrossRef]
- Kim, J.-W.; Park, K.-W.; Kim, M.; Lee, K.K.; Lee, C.-S. Highly Specific Loop-Mediated Isothermal Amplification Using Graphene Oxide–Gold Nanoparticles Nanocomposite for Foot-and-Mouth Disease Virus Detection. Nanomaterials 2022, 12, 264. [Google Scholar] [CrossRef]
- Li, J.; Jiang, J.; Zhao, D.; Xu, Z.; Liu, M.; Liu, X.; Tong, H.; Qian, D. Novel hierarchical sea urchin-like Prussian blue@ palladium core–shell heterostructures supported on nitrogen-doped reduced graphene oxide: Facile synthesis and excellent guanine sensing performance. Electrochim. Acta 2020, 330, 135196. [Google Scholar] [CrossRef]
- Wang, Y.; Wang, Y.; Jiao, W.; Li, J.; Quan, S.; Sun, L.; Wang, Y.; Qi, X.; Wang, X.; Shen, A. Development of loop-mediated isothermal amplification coupled with nanoparticle-based lateral flow biosensor assay for Mycoplasma pneumoniae detection. AMB Express 2019, 9, 196. [Google Scholar] [CrossRef]
- Tao, Y.; Ran, X.; Ren, J.; Qu, X. Array-Based Sensing of Proteins and Bacteria By Using Multiple Luminescent Nanodots as Fluorescent Probes. Small 2014, 10, 3667–3671. [Google Scholar] [CrossRef] [PubMed]
- Péter, B.; Farkas, E.; Kurunczi, S.; Szittner, Z.; Bősze, S.; Ramsden, J.J.; Szekacs, I.; Horvath, R. Review of Label-Free Monitoring of Bacteria: From Challenging Practical Applications to Basic Research Perspectives. Biosensors 2022, 12, 188. [Google Scholar] [CrossRef] [PubMed]
- Roostaee, M.; Sheikhshoaie, I. Fabrication of a sensitive sensor for determination of xanthine in the presence of uric acid and ascorbic acid by modifying a carbon paste sensor with Fe3O4@ Au core–shell and an ionic liquid. J. Food Meas. Charact. 2022, 16, 731–739. [Google Scholar] [CrossRef]
- Shabani-Nooshabadi, M.; Roostaee, M. Coupling of NiO nanoparticles and room temperature ionic liquid for fabrication of highly sensitive voltammetric sensor in tryptophan analysis. Anal. Bioanal. Electrochem 2016, 8, 578–588. [Google Scholar]
- Nirgund, J.; Purana, K.; Selvakumar, D.; Kumar, N.; Sil, S. Nanobiosensors for detection of bacteria: An overview of fiber-optics and Raman spectroscopy based biosensors. In Handbook of Microbial Nanotechnology; Academic Press: Cambridge, MA, USA, 2022; pp. 91–132. [Google Scholar]
- Sargazi, S.; Mukhtar, M.; Rahdar, A.; Bilal, M.; Barani, M.; Díez-Pascual, A.M.; Behzadmehr, R.; Pandey, S. Opportunities and challenges of using high-sensitivity nanobiosensors to detect long noncoding RNAs: A preliminary review. Int. J. Biol. Macromol. 2022, 205, 304–315. [Google Scholar] [CrossRef]
- Li, B.; Li, X.; Dong, Y.; Wang, B.; Li, D.; Shi, Y.; Wu, Y. Colorimetric sensor array based on gold nanoparticles with diverse surface charges for microorganisms identification. Anal. Chem. 2017, 89, 10639–10643. [Google Scholar] [CrossRef]
- Ahmed, A.; Rushworth, J.V.; Hirst, N.A.; Millner, P.A. Biosensors for whole-cell bacterial detection. Clin. Microbiol. Rev. 2014, 27, 631. [Google Scholar] [CrossRef]
- Liu, T.-Y.; Tsai, K.-T.; Wang, H.-H.; Chen, Y.; Chen, Y.-H.; Chao, Y.-C.; Chang, H.-H.; Lin, C.-H.; Wang, J.-K.; Wang, Y.-L. Functionalized arrays of Raman-enhancing nanoparticles for capture and culture-free analysis of bacteria in human blood. Nat. Commun. 2011, 2, 538. [Google Scholar] [CrossRef]
- Maldonado, J.; Estévez, M.-C.; Fernández-Gavela, A.; González-López, J.J.; González-Guerrero, A.B.; Lechuga, L.M. Label-free detection of nosocomial bacteria using a nanophotonic interferometric biosensor. Analyst 2020, 145, 497–506. [Google Scholar] [CrossRef]
- Cheong, Y.; Kim, Y.J.; Kang, H.; Choi, S.; Lee, H.J. Rapid label-free identification of Klebsiella pneumoniae antibiotic resistant strains by the drop-coating deposition surface-enhanced Raman scattering method. Spectrochim. Acta Part A Mol. Biomol. Spectrosc. 2017, 183, 53–59. [Google Scholar] [CrossRef] [PubMed]
- Huang, L.-S.; Pheanpanitporn, Y.; Yen, Y.-K.; Chang, K.-F.; Lin, L.-Y.; Lai, D.-M. Detection of the antiepileptic drug phenytoin using a single free-standing piezoresistive microcantilever for therapeutic drug monitoring. Biosens. Bioelectron. 2014, 59, 233–238. [Google Scholar] [CrossRef] [PubMed]
- Zheng, F.; Wang, P.; Du, Q.; Chen, Y.; Liu, N. Simultaneous and ultrasensitive detection of foodborne bacteria by gold nanoparticles-amplified microcantilever array biosensor. Front. Chem. 2019, 7, 232. [Google Scholar] [CrossRef] [PubMed]
- Arshad, R.; Barani, M.; Rahdar, A.; Sargazi, S.; Cucchiarini, M.; Pandey, S.; Kang, M. Multi-functionalized nanomaterials and nanoparticles for diagnosis and treatment of retinoblastoma. Biosensors 2021, 11, 97. [Google Scholar] [CrossRef]
- Marinesco, S. Microelectrode Biosensors for In Vivo Functional Monitoring of Biological Molecules. In Reference Module in Chemistry, Molecular Sciences and Chemical Engineering; Elsevier: Amsterdam, The Netherlands, 2018. [Google Scholar]
- Zhang, Z.; Yu, H.-W.; Wan, G.-C.; Jiang, J.-H.; Wang, N.; Liu, Z.-Y.; Chang, D.; Pan, H.-Z. A Label-Free Electrochemical Biosensor Based on a Reduced Graphene Oxide and Indole-5-Carboxylic Acid Nanocomposite for the Detection of Klebsiella pneumoniae. J. AOAC Int. 2017, 100, 548–552. [Google Scholar] [CrossRef]
- Pan, H.-z.; Yu, H.-w.; Wang, N.; Zhang, Z.; Wan, G.-c.; Liu, H.; Guan, X.; Chang, D. Electrochemical DNA biosensor based on a glassy carbon electrode modified with gold nanoparticles and graphene for sensitive determination of Klebsiella pneumoniae carbapenemase. J. Biotechnol. 2015, 214, 133–138. [Google Scholar] [CrossRef]
- Lu, L.; Hu, X.; Zhu, Z. Biomimetic sensors and biosensors for qualitative and quantitative analyses of five basic tastes. TRAC Trends Anal. Chem. 2017, 87, 58–70. [Google Scholar] [CrossRef]
- Li, B.; Tan, H.; Anastasova, S.; Power, M.; Seichepine, F.; Yang, G.-Z. A bio-inspired 3D micro-structure for graphene-based bacteria sensing. Biosens. Bioelectron. 2019, 123, 77–84. [Google Scholar] [CrossRef]
- Chen, X.; Zhou, Q.; Dong, S.; Wang, S.; Liu, R.; Wu, X.; Li, S. Multiple cross displacement amplification linked with nanoparticles-based lateral flow biosensor in screening of hepatitis B virus in clinical application. Infect. Drug Resist. 2021, 14, 1219. [Google Scholar] [CrossRef]
- Aylott, J.W. Optical nanosensors—an enabling technology for intracellular measurements. Analyst 2003, 128, 309–312. [Google Scholar] [CrossRef]
- Fritz, J. Cantilever biosensors. Analyst 2008, 133, 855–863. [Google Scholar] [CrossRef] [PubMed]
- Riu, J.; Giussani, B. Electrochemical biosensors for the detection of pathogenic bacteria in food. TrAC Trends Anal. Chem. 2020, 126, 115863. [Google Scholar] [CrossRef]
- O’Neill, J. Tackling Drug-Resistant Infections Globally: Final Report and Recommendations. 2016. Available online: https://amr-review.org/sites/default/files/160518_Final%20paper_with%20cover.pdf (accessed on 1 December 2022).
- Dakal, T.C.; Kumar, A.; Majumdar, R.S.; Yadav, V. Mechanistic basis of antimicrobial actions of silver nanoparticles. Front. Microbiol. 2016, 7, 1831. [Google Scholar] [CrossRef] [PubMed]
- Singaravelu, D.K.; Binjawhar, D.N.; Ameen, F.; Veerappan, A. Lectin-Fortified Cationic Copper Sulfide Nanoparticles Gain Dual Targeting Capabilities to Treat Carbapenem-Resistant Acinetobacter baumannii Infection. ACS Omega 2022, 7, 43934–43944. [Google Scholar] [CrossRef]
- Gour, A.; Jain, N.K. Advances in green synthesis of nanoparticles. Artif. Cells Nanomed. Biotechnol. 2019, 47, 844–851. [Google Scholar] [CrossRef]
- Dong, H.; Gao, Y.; Sinko, P.J.; Wu, Z.; Xu, J.; Jia, L. The nanotechnology race between China and the United States. Nano Today 2016, 11, 7–12. [Google Scholar] [CrossRef]
- Lai, W.-F.; Tang, R.; Wong, W.-T. Ionically crosslinked complex gels loaded with oleic acid-containing vesicles for transdermal drug delivery. Pharmaceutics 2020, 12, 725. [Google Scholar] [CrossRef]
- Megarajan, S.; Ameen, F.; Singaravelu, D.; Islam, M.A.; Veerappan, A. Synthesis of N-myristoyltaurine stabilized gold and silver nanoparticles: Assessment of their catalytic activity, antimicrobial effectiveness and toxicity in zebrafish. Environ. Res. 2022, 212, 113159. [Google Scholar] [CrossRef]
- Begum, I.; Ameen, F.; Soomro, Z.; Shamim, S.; AlNadhari, S.; Almansob, A.; Al-Sabri, A.; Arif, A. Facile fabrication of malonic acid capped silver nanoparticles and their antibacterial activity. J. King Saud. Univ. -Sci. 2021, 33, 101231. [Google Scholar] [CrossRef]
- Hamida, R.S.; Ali, M.A.; Goda, D.A.; Khalil, M.I.; Al-Zaban, M.I. Novel biogenic silver nanoparticle-induced reactive oxygen species inhibit the biofilm formation and virulence activities of Methicillin-Resistant Staphylococcus aureus (MRSA) strain. Front. Bioeng. Biotechnol. 2020, 8, 433. [Google Scholar] [CrossRef]
- Yang, T.-Y.; Hsieh, Y.-J.; Lu, P.-L.; Lin, L.; Wang, L.-C.; Wang, H.-Y.; Tsai, T.-H.; Shih, C.-J.; Tseng, S.-P. In vitro and in vivo assessments of inspired ag/80S bioactive nanocomposites against carbapenem-resistant Klebsiella pneumoniae. Mater. Sci. Eng. C 2021, 125, 112093. [Google Scholar] [CrossRef] [PubMed]
- Dolatabadi, A.; Noorbazargan, H.; Khayam, N.; Moulavi, P.; Zamani, N.; Asghari Lalami, Z.; Ashrafi, F. Ecofriendly Biomolecule-Capped Bifidobacterium bifidum-Manufactured Silver Nanoparticles and Efflux Pump Genes Expression Alteration in Klebsiella pneumoniae. Microb. Drug Resist. 2021, 27, 247–257. [Google Scholar] [CrossRef] [PubMed]
- Chhibber, S.; Gondil, V.S.; Singla, L.; Kumar, M.; Chhibber, T.; Sharma, G.; Sharma, R.K.; Wangoo, N.; Katare, O.P. Effective topical delivery of H-AgNPs for eradication of Klebsiella pneumoniae–induced burn wound infection. AAPS Pharm. Sci. Tech. 2019, 20, 169. [Google Scholar] [CrossRef] [PubMed]
- El-kaliuoby, M.I.; Khalil, A.M.; El-Khatib, A.M.; Shalaby, T.I. Synergistic Antibacterial Effect of Silver Nanoparticles and Extremely Low-Frequency Pulsed Magnetic Fields on Klebsiella pneumoniae. Communications 2018, 15, 23. [Google Scholar]
- Kotlhao, K.; Madiseng, M.D.; Mtunzi, F.M.; Pakade, V.E.; Modise, S.J.; Laloo, N.; Klink, M.J. The synthesis of silver, zinc oxide and titanium dioxide nanoparticles and their antimicrobial activity. In Proceedings of the Advanced Materials Proceedings, Stockholm, Sweden, 1 August 2017; pp. 479–484. [Google Scholar]
- Ciobanu, C.S.; Iconaru, S.L.; Le Coustumer, P.; Constantin, L.V.; Predoi, D. Antibacterial activity of silver-doped hydroxyapatite nanoparticles against gram-positive and gram-negative bacteria. Nanoscale Res. Lett. 2012, 7, 324. [Google Scholar] [CrossRef] [PubMed]
- Naqvi, S.Z.H.; Kiran, U.; Ali, M.I.; Jamal, A.; Hameed, A.; Ahmed, S.; Ali, N. Combined efficacy of biologically synthesized silver nanoparticles and different antibiotics against multidrug-resistant bacteria. Int. J. Nanomed. 2013, 8, 3187. [Google Scholar] [CrossRef] [PubMed]
- Ahmed, A.; Khan, A.K.; Anwar, A.; Ali, S.A.; Shah, M.R. Biofilm inhibitory effect of chlorhexidine conjugated gold nanoparticles against Klebsiella pneumoniae. Microb. Pathog. 2016, 98, 50–56. [Google Scholar] [CrossRef]
- Yousef, J.M.; Danial, E.N. In vitro antibacterial activity and minimum inhibitory concentration of zinc oxide and nano-particle zinc oxide against pathogenic strains. J. Health Sci. 2012, 2, 38–42. [Google Scholar] [CrossRef]
- Hameed, A.S.H.; Karthikeyan, C.; Ahamed, A.P.; Thajuddin, N.; Alharbi, N.S.; Alharbi, S.A.; Ravi, G. In vitro antibacterial activity of ZnO and Nd doped ZnO nanoparticles against ESBL producing Escherichia coli and Klebsiella pneumoniae. Sci. Rep. 2016, 6, 24312. [Google Scholar] [CrossRef]
- Venkatasubbu, G.D.; Baskar, R.; Anusuya, T.; Seshan, C.A.; Chelliah, R. Toxicity mechanism of titanium dioxide and zinc oxide nanoparticles against food pathogens. Colloids Surf. B Biointerfaces 2016, 148, 600–606. [Google Scholar] [CrossRef]
- Thakur, B.; Kumar, A.; Kumar, D. Green synthesis of titanium dioxide nanoparticles using Azadirachta indica leaf extract and evaluation of their antibacterial activity. South Afr. J. Bot. 2019, 124, 223–227. [Google Scholar] [CrossRef]
- Yousef, A.; Barakat, N.A.; Amna, T.; Al-Deyab, S.S.; Hassan, M.S.; Abdel-Hay, A.; Kim, H.Y. Inactivation of pathogenic Klebsiella pneumoniae by CuO/TiO2 nanofibers: A multifunctional nanomaterial via one-step electrospinning. Ceram. Int. 2012, 38, 4525–4532. [Google Scholar] [CrossRef]
- Kumar, A.; Singh, S.; Kumar, D. Evaluation of antimicrobial potential of cadmium sulphide nanoparticles against bacterial pathogens. Int. J. Pharm. Sci. Rev. Res 2014, 24, n32. [Google Scholar]
- Xu, N.; Lu, W.; Meng, L.; Feng, X.; Xuan, J.; Liu, F.; Feng, Z. Carbonic anhydrase inhibition, antioxidant activity against alveolar epithelial cells and antibacterial effect against Klebsiella pneumoniae enabled by synthesized silica nanoparticles through laser ablation technique. Life Sci. 2021, 278, 119032. [Google Scholar] [CrossRef] [PubMed]
- Rahman, K.U.; Ferreira-Neto, E.P.; Rahman, G.U.; Parveen, R.; Monteiro, A.S.; Rahman, G.; Van Le, Q.; Domeneguetti, R.R.; Ribeiro, S.J.; Ullah, S. Flexible bacterial cellulose-based BC-SiO2-TiO2-Ag membranes with self-cleaning, photocatalytic, antibacterial and UV-shielding properties as a potential multifunctional material for combating infections and environmental applications. J. Environ. Chem. Eng. 2021, 9, 104708. [Google Scholar] [CrossRef]
- Al Edhari, B.; Mashreghi, M.; Makhdoumi, A.; Darroudi, M. Antibacterial and antibiofilm efficacy of Ag NPs, Ni NPs and Al2O3 NPs singly and in combination against multidrug-resistant Klebsiella pneumoniae isolates. J. Trace Elem. Med. Biol. 2021, 68, 126840. [Google Scholar] [CrossRef]
- Ramsden, J.J. Photocatalytic antimicrobial coatings. Nanotechnol. Percept. 2015, 11, 146–168. [Google Scholar] [CrossRef]
- Reid, M.; Whatley, V.; Spooner, E.; Nevill, A.M.; Cooper, M.; Ramsden, J.J.; Dancer, S.J. How does a photocatalytic antimicrobial coating affect environmental bioburden in hospitals? Infect. Control. Hosp. Epidemiol. 2018, 39, 398–404. [Google Scholar] [CrossRef]
- Farooq, U.; Ahmad, T.; Khan, A.; Sarwar, R.; Shafiq, J.; Raza, Y.; Ahmed, A.; Ullah, S.; Rehman, N.U.; Al-Harrasi, A. Rifampicin conjugated silver nanoparticles: A new arena for development of antibiofilm potential against methicillin resistant Staphylococcus aureus and Klebsiella pneumoniae. Int. J. Nanomed. 2019, 14, 3983. [Google Scholar] [CrossRef]
- Chhibber, S.; Gondil, V.S.; Sharma, S.; Kumar, M.; Wangoo, N.; Sharma, R.K. A novel approach for combating Klebsiella pneumoniae biofilm using histidine functionalized silver nanoparticles. Front. Microbiol. 2017, 8, 1104. [Google Scholar] [CrossRef]
- Abdel-Aziz, M.M.; Yosri, M.; Amin, B.H. Control of imipenem resistant-Klebsiella pneumoniae pulmonary infection by oral treatment using a combination of mycosynthesized Ag-nanoparticles and imipenem. J. Radiat. Res. Appl. Sci. 2017, 10, 353–360. [Google Scholar] [CrossRef][Green Version]
- Shanmugaiah, V.; Harikrishnan, H.; Al-Harbi, N.; Shine, K.; Khaled, J.; Balasubramanian, N.; Kumar, R.S. Facile synthesis of silver nanoparticles using Streptomyces sp. VSMGT1014 and their antimicrobial efficiency. Dig. J. Nanomater. Biostruct. 2015, 10, 179–187. [Google Scholar]
- Saravanan, M.; Arokiyaraj, S.; Lakshmi, T.; Pugazhendhi, A. Synthesis of silver nanoparticles from Phenerochaete chrysosporium (MTCC-787) and their antibacterial activity against human pathogenic bacteria. Microb. Pathog. 2018, 117, 68–72. [Google Scholar] [CrossRef] [PubMed]
- Cao, S.; Wu, X.; Zhao, J.; Jia, X. Clinical Study of the Treatment of Klebsiella pneumoniae with Comprehensive Nursing Intervention Combined with New Nano Silver. J. Nanosci. Nanotechnol. 2020, 20, 6063–6069. [Google Scholar] [CrossRef] [PubMed]
- Kareem, P.A.; Alsammak, E.G. The effect of silver and titanium dioxide nanoparticles on Klebsiella pneumoniae isolates multi resistant to antibiotics and observed by scanning electron microscopy. Cihan Univ. Sci. J. 2017, 2017, 284–297. [Google Scholar] [CrossRef][Green Version]
- Kőrösi, L.; Dömötör, D.; Beke, S.; Prato, M.; Scarpellini, A.; Meczker, K.; Schneider, G.; Kovács, T.; Kovács, Á.; Papp, S. Antibacterial activity of nanocrystalline TiO2 (B) on multiresistant Klebsiella pneumoniae strains. Sci. Adv. Mater. 2013, 5, 1184–1192. [Google Scholar] [CrossRef]
- Maheswari, P.; Harish, S.; Navaneethan, M.; Muthamizhchelvan, C.; Ponnusamy, S.; Hayakawa, Y. Bio-modified TiO2 nanoparticles with Withania somnifera, Eclipta prostrata and Glycyrrhiza glabra for anticancer and antibacterial applications. Mater. Sci. Eng. C 2020, 108, 110457. [Google Scholar] [CrossRef]
- Shafiei, M.; Amini, K.; Jafari, P. Impact of Probiotic Lactococcus lactis and Titanium Dioxide Nanoparticles on the Expression of Klebsiella pneumoniae Biofilm Genes; a Comparative Study. Mol. Genet. Microbiol. Virol. 2021, 36, 46–52. [Google Scholar] [CrossRef]
- Shirzadi-Ahodashti, M.; Mortazavi-Derazkola, S.; Ebrahimzadeh, M.A. Biosynthesis of noble metal nanoparticles using crataegus monogyna leaf extract (CML@ X-NPs, X= Ag, Au): Antibacterial and cytotoxic activities against breast and gastric cancer cell lines. Surf. Interfaces 2020, 21, 100697. [Google Scholar] [CrossRef]
- Picoli, S.U.; Durán, M.; Andrade, P.F.; Duran, N. Silver nanoparticles/silver chloride (Ag/AgCl) synthesized from Fusarium oxysporum acting against Klebsiella pneumouniae carbapenemase (KPC) and extended spectrum beta-lactamase (ESBL). Front. Nanosci. Nanotech. 2016, 2, 107–110. [Google Scholar] [CrossRef]
- El-Rab, S.M.G.; Abo-Amer, A.E.; Asiri, A.M. Biogenic synthesis of ZnO nanoparticles and its potential use as antimicrobial agent against multidrug-resistant pathogens. Curr. Microbiol. 2020, 77, 1767–1779. [Google Scholar] [CrossRef] [PubMed]
- Rasha, E.; Monerah, A.; Manal, A.; Rehab, A.; Mohammed, D.; Doaa, E. Biosynthesis of Zinc Oxide Nanoparticles from Acacia nilotica (L.) Extract to Overcome Carbapenem-Resistant Klebsiella Pneumoniae. Molecules 2021, 26, 1919. [Google Scholar] [CrossRef] [PubMed]
- Chouke, P.; Potbhare, A.; Dadure, K.; Mungole, A.; Meshram, N.; Chaudhary, R.; Rai, A.; Chaudhary, R. An antibacterial activity of Bauhinia racemosa assisted ZnO nanoparticles during lunar eclipse and docking assay. Mater. Today Proc. 2020, 29, 815–821. [Google Scholar] [CrossRef]
- Meenatchi, T.; Palanimurugan, A.; Dhanalakshmi, A.; Maheshkumar, V.; Natarajan, B. Green synthesis of Cynodon Dactylon capped concentrations on ZnO nanoparticles for antibacterial activity, ROS/ML-DNA treatment and compilation of best controlling microbes by mathematical comparisons. Chem. Phys. Lett. 2020, 749, 137429. [Google Scholar] [CrossRef]
- Vidhya, E.; Vijayakumar, S.; Prathipkumar, S.; Praseetha, P. Green way biosynthesis: Characterization, antimicrobial and anticancer activity of ZnO nanoparticles. Gene Rep. 2020, 20, 100688. [Google Scholar] [CrossRef]
- Reddy, L.S.; Nisha, M.M.; Joice, M.; Shilpa, P. Antimicrobial activity of zinc oxide (ZnO) nanoparticle against Klebsiella pneumoniae. Pharm. Biol. 2014, 52, 1388–1397. [Google Scholar] [CrossRef]
- Prasad, A.R.; Basheer, S.M.; Gupta, I.R.; Elyas, K.; Joseph, A. Investigation on bovine serum albumin (BSA) binding efficiency and antibacterial activity of ZnO nanoparticles. Mater. Chem. Phys. 2020, 240, 122115. [Google Scholar] [CrossRef]
- Partoazar, A.; Bideskan, F.R.; Takzaree, N.; Dallal, M. Antibiofilm Activity of ZnO/Zeolite Nanocomposite (ZnO/ZeoNC) Against Klebsiella pneumoniae and its Biocompatibility in an Animal Model. Anti-Infect. Agents 2021, 19, 174–181. [Google Scholar] [CrossRef]
- Dhas, S.P.; Shiny, P.J.; Khan, S.; Mukherjee, A.; Chandrasekaran, N. Toxic behavior of silver and zinc oxide nanoparticles on environmental microorganisms. J. Basic Microbiol. 2014, 54, 916–927. [Google Scholar] [CrossRef]
- Chandra, H.; Patel, D.; Kumari, P.; Jangwan, J.; Yadav, S. Phyto-mediated synthesis of zinc oxide nanoparticles of Berberis aristata: Characterization, antioxidant activity and antibacterial activity with special reference to urinary tract pathogens. Mater. Sci. Eng. C 2019, 102, 212–220. [Google Scholar] [CrossRef]
- Nadeem, M.S.; Munawar, T.; Mukhtar, F.; Ur Rahman, M.N.; Riaz, M.; Iqbal, F. Enhancement in the photocatalytic and antimicrobial properties of ZnO nanoparticles by structural variations and energy bandgap tuning through Fe and Co co-doping. Ceram. Int. 2021, 47, 11109–11121. [Google Scholar] [CrossRef]
- Sharifuddin, S.A.B.; Ismail, S.B.; Abdullah, I.; Mohamad, I.; Mohammed, J.S. Antibacterial evaluation of activated carbon cloth with Ag+ impregnated with ZnO nanoparticles. Res. J. Text. Appar. 2019, 23, 232–243. [Google Scholar] [CrossRef]
- Sathish, P.; Dineshbabu, N.; Ravichandran, K.; Arun, T.; Karuppasamy, P.; SenthilPandian, M.; Ramasamy, P. Combustion synthesis, characterization and antibacterial properties of pristine ZnO and Ga doped ZnO nanoparticles. Ceram. Int. 2021, 47, 27934–27941. [Google Scholar] [CrossRef]
- Zheng, L.P.; Zhang, Z.; Zhang, B.; Wang, J.W. Antifungal properties of Ag-SiO2 core-shell nanoparticles against phytopathogenic fungi. Adv. Mat. Res. 2012, 476, 814–818. [Google Scholar]
- Zahid, M.; Papadopoulou, E.L.; Suarato, G.; Binas, V.D.; Kiriakidis, G.; Gounaki, I.; Moira, O.; Venieri, D.; Bayer, I.S.; Athanassiou, A. Fabrication of visible light-induced antibacterial and self-cleaning cotton fabrics using manganese doped TiO2 nanoparticles. ACS Appl. Bio Mater. 2018, 1, 1154–1164. [Google Scholar] [CrossRef]
- Ryu, S.-Y.; Chung, J.W.; Kwak, S.-Y. Dependence of photocatalytic and antimicrobial activity of electrospun polymeric nanofiber composites on the positioning of Ag–TiO2 nanoparticles. Compos. Sci. Technol. 2015, 117, 9–17. [Google Scholar] [CrossRef]
- Huang, S.-M.; Weng, C.-H.; Tzeng, J.-H.; Huang, Y.-Z.; Anotai, J.; Yen, L.-T.; Chang, C.-J.; Lin, Y.-T. Photocatalytic inactivation of Klebsiella pneumoniae by visible-light-responsive N/C-doped and N-tourmaline/palladium-C-codoped TiO2. Chem. Eng. J. 2020, 379, 122345. [Google Scholar] [CrossRef]
- Ramakritinan, C.; Kaarunya, E.; Shankar, S.; Kumaraguru, A. Antibacterial effects of Ag, Au and bimetallic (Ag-Au) nanoparticles synthesized from red algae. Solid State Phenom. 2013, 201, 211–230. [Google Scholar] [CrossRef]
- Zhao, X.; Jia, Y.; Li, J.; Dong, R.; Zhang, J.; Ma, C.; Wang, H.; Rui, Y.; Jiang, X. Indole derivative-capped gold nanoparticles as an effective bactericide in vivo. ACS Appl. Mater. Interfaces 2018, 10, 29398–29406. [Google Scholar] [CrossRef]
- Ansari, S.A.; Oves, M.; Satar, R.; Khan, A.; Ahmad, S.I.; Jafri, M.A.; Zaidi, S.K.; Algahtani, M. Antibacterial activity of iron oxide nanoparticles synthesized by co-precipitation technology against Bacillus cereus and Klebsiella pneumoniae. Pol. J. Chem. Technol. 2017, 19, 110–115. [Google Scholar] [CrossRef]

| Detection Method | Principle | Advantage | Disadvantage | Ref. |
|---|---|---|---|---|
| Multiplex polymerase chain reaction | Multiple targets can be detected simultaneously in a single reaction using separate primers for each target and using two or more probes. |
|
| [52] |
| DNA microarray | A group of microscopic DNA patches is used to genotype different parts of a genome or to evaluate the expression levels of several genes at once linked to a solid surface. |
|
| [53] |
| Single-colony whole-genome sequencing | The process determines the DNA sequence of an entire genome and a brute-force approach to problem-solving uses a genetic basis at the core of a disease. |
|
| [44] |
| Raman spectroscopic analysis | This uses light to stimulate (produce) molecular vibration in a sample, then interprets this interaction to perform a chemical analysis. It is based on the inelastic scattering of light that takes place when light interacts with matter. |
|
| [54] |
| Loop-mediated isothermal amplification (LAMP) | Amplifies DNA under isothermal conditions by using a DNA polymerase with high displacement strand activity and a set of specifically designed primers to amplify targeted DNA strands. |
|
| [55] |
| Chromogenic media | Inclusion of chromogenic enzyme substrates targeting microbial enzymes |
|
| [56] |
| Detection Method | Principle | Advantage | Disadvantage | Ref. |
|---|---|---|---|---|
| Nanoparticle-assisted multiple cross-displacement amplification | Amplifies the circular DNA template with the use of random primers and DNA polymerase. Within a few hours, the DNA may be amplified over 10,000 times. |
|
| [92] |
| Optical nanosensors | Utilizes the altered optical characteristics of the nanometric surface of the sensor brought about by the bound analyte, and these altered optical characteristics are then sent to a detector. |
|
| [93] |
| Cantilever-based nanosensors | A biomolecular interaction produces a change in the mechanical behavior of the transducer (a movement at nanometer scale), which can be measured and analyzed in real time. |
|
| [94] |
| Electrochemical nanosensors | Transforms the interaction of an analyte with a receptor on the surface of an electrode into a useful analytical signal. |
|
| [95] |
Publisher’s Note: MDPI stays neutral with regard to jurisdictional claims in published maps and institutional affiliations. |
© 2022 by the authors. Licensee MDPI, Basel, Switzerland. This article is an open access article distributed under the terms and conditions of the Creative Commons Attribution (CC BY) license (https://creativecommons.org/licenses/by/4.0/).
Share and Cite
Barani, M.; Fathizadeh, H.; Arkaban, H.; Kalantar-Neyestanaki, D.; Akbarizadeh, M.R.; Turki Jalil, A.; Akhavan-Sigari, R. Recent Advances in Nanotechnology for the Management of Klebsiella pneumoniae–Related Infections. Biosensors 2022, 12, 1155. https://doi.org/10.3390/bios12121155
Barani M, Fathizadeh H, Arkaban H, Kalantar-Neyestanaki D, Akbarizadeh MR, Turki Jalil A, Akhavan-Sigari R. Recent Advances in Nanotechnology for the Management of Klebsiella pneumoniae–Related Infections. Biosensors. 2022; 12(12):1155. https://doi.org/10.3390/bios12121155
Chicago/Turabian StyleBarani, Mahmood, Hadis Fathizadeh, Hassan Arkaban, Davood Kalantar-Neyestanaki, Majid Reza Akbarizadeh, Abduladheem Turki Jalil, and Reza Akhavan-Sigari. 2022. "Recent Advances in Nanotechnology for the Management of Klebsiella pneumoniae–Related Infections" Biosensors 12, no. 12: 1155. https://doi.org/10.3390/bios12121155
APA StyleBarani, M., Fathizadeh, H., Arkaban, H., Kalantar-Neyestanaki, D., Akbarizadeh, M. R., Turki Jalil, A., & Akhavan-Sigari, R. (2022). Recent Advances in Nanotechnology for the Management of Klebsiella pneumoniae–Related Infections. Biosensors, 12(12), 1155. https://doi.org/10.3390/bios12121155







